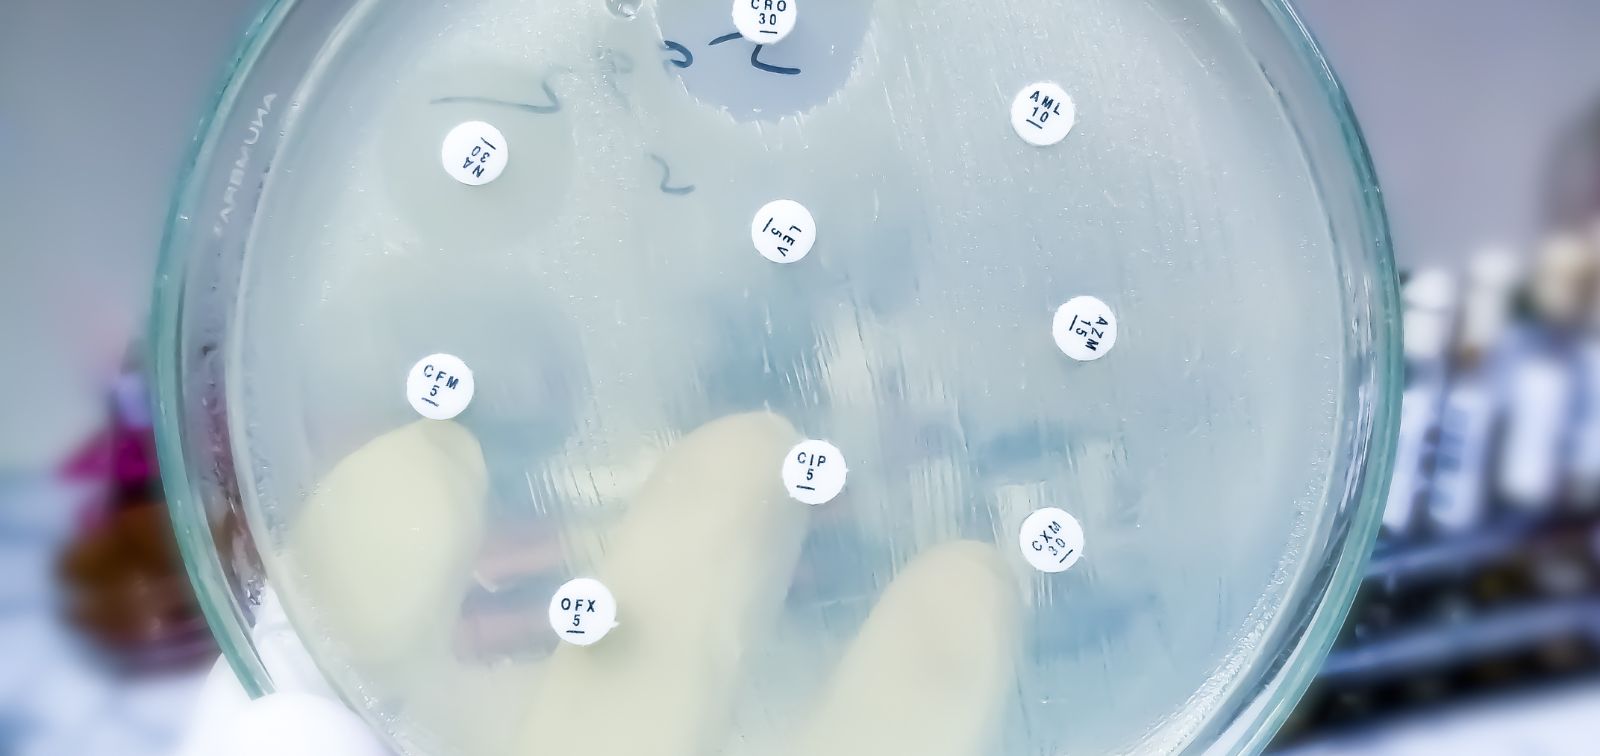
FINDOOR project

FINDOOR
FTIR spectroscopy for real-time detection of bacterial outbreaks and the rapid identification of pathogenic serotypes, relapsing infections and antibiotic resistance
- Duration
- 01/09/2022 - 31/08/2026
- Coordinator
- Ignasi Roca
- Funded by
- Ministerio de Ciencia, Innovación y Universidades / Unión Europea / Agencia Estatal de Investigación (Ayuda PID2021-127402OB-I00)
The rise of antibiotic resistance represents a serious public health issue, and it is increasingly common to encounter patients with infections caused by bacteria that cannot be treated with any available antibiotic. This issue results in longer hospitalization times and associated mortality. The increase of hospital infections and resistance over all is mainly associated with the group of pathogenic bacteria known as ESKAPE, for their ability to evade the effect of antibiotics and to disseminate within hospitals. It is urgent to develop novel therapeutic strategies to treat patients infected by these microorganisms, but the prompt identification of such pathogens is also essential in order to preserve critical antibiotics and to rapidly activate prevention and infection control measures to contain their further spread.
During the last three years our team has monitored and collected the main antibiotic resistant bacteria spreading among a network of 22 healthcare facilities within Catalonia. We have identified the main mechanisms of resistance and the different clonal lineages disseminating in our centers. Nevertheless, we still lack a tool to identify such high-risk clones in order to implement control measures fast enough.
In this project we intend to use Fourier-transform Infrared (FTIR) spectroscopy to determine the clonal relatedness of bacterial isolates in real-time. This method detects the absorption of infrared light associated with the molecular vibration of the different molecules within the sample, thus generating a particular spectrum that constitutes a fingerprint for each strain. Bacterial isolates from the same clonal lineage or that share certain characteristics, such as antibiotic resistance, will show a similar absorption profile and we will be able to quantify their degree of relatedness and cluster them into particular categories, such as species, clonal group, capsular type, or resistance against a particular antibiotic. Therefore, by combining genomic, clinical and phenotypic data together with FTIR spectra, we will generate a database that should allow us to analyze the local epidemiology of all participant hospitals as well as to identify almost immediately (in real-time) any new isolate and relate it to the main circulating ESKAPE clones or identify certain characteristics that are of clinical relevance.
In the short run, such methodology should allow the rapid detection of bacterial outbreaks, thus reducing the time to activate prevention and infection control measures and improving our ability to prevent the spread of ESKAPE pathogens.
In the long run, we aim at reducing morbidity and mortality associated with infectious diseases caused by ESKAPE microorganisms as well as improve our understanding of the local epidemiology of such bacteria and their main transmission routes.
Total Fuding
108.900,00 €
Other projects
ENDOMIX
Understanding how endocrine disruptors and chemical mixtures of concern target the immune system to trigger or perpetuate disease
AM-MENTAL
What happens with your mental health when your supervisor is an algorithm?
PANAMA
Inhaled dose of air pollution - an integrative approach towards personalized air pollution exposure assessment in participants with and without respiratory diseases
e-QuoL
e-health tools to promote Equality in Quality of Life for childhood to young adulthood cancer patients, survivors and their families
B-Triage
Una prueba en el punto de atención para la estratificación del riesgo de los pacientes febriles basada en los niveles de sTREM-1
El microbioma intestinal y la disrupción circadiana
Un estudio epidemiológico molecular sobre enfermedades cardiometabólicas y salud mental
IHEN
International Human Exposome Network
EXPONIT
Analysing and studying how night shift work affects workers' circadian rhythms and health

